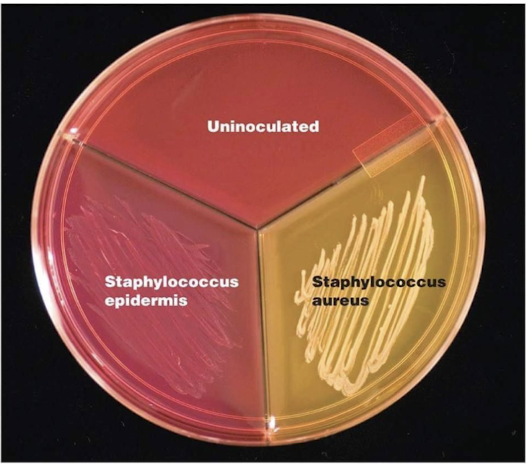
<p>It contains mannitol and a pH indicator (phenol red), where fermentation produces acid, turning the medium yellow.</p>
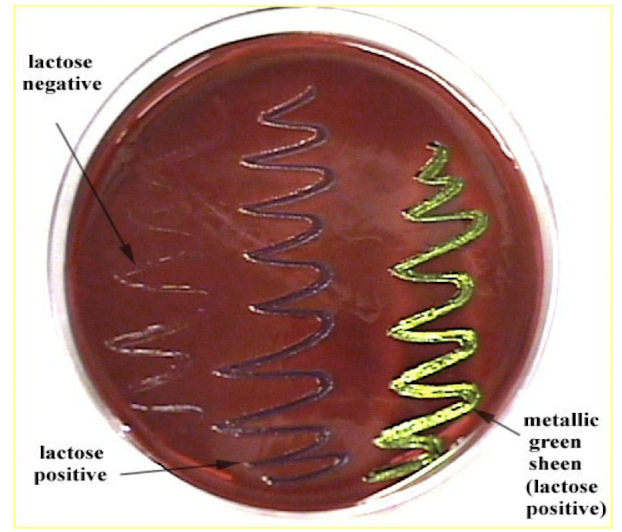
<p>Lactose fermenters produce dark purple/black colonies, sometimes with a metallic green sheen, while non-fermenters remain colorless.</p>

1/121
Looks like no tags are added yet.
Name | Mastery | Learn | Test | Matching | Spaced | Call with Kai |
|---|
No analytics yet
Send a link to your students to track their progress
What are bacteria?
Bacteria are single-celled, prokaryotic organisms that lack a nucleus and membrane-bound organelles, containing circular DNA in a nucleoid region and typically possessing a rigid cell wall.
How are prokaryotic cells different from eukaryotic cells?
Prokaryotic cells are smaller, lack a nucleus and organelles, and contain “naked” circular DNA, whereas eukaryotic cells have a defined nucleus and complex internal structures.

What structural components are commonly found in bacteria?
Bacteria commonly have a cell wall for rigidity, a plasma membrane, ribosomes, and may have structures such as flagella for motility, pili for adherence, and capsules for pathogenicity.
How are bacteria classified?
Bacteria are classified based on shape/structure, cell wall composition, gaseous requirements, nutritional patterns, and their interaction with the host.
What are the main bacterial shapes?
Bacteria can be classified by shape into cocci (spherical), bacilli (rod-shaped), curved forms such as vibrio, spiral forms such as spirilla and spirochetes, and other specialized shapes.

What are examples of bacterial arrangements?
Cocci may appear in pairs (diplo-), chains (strepto-), or clusters (staphylo-), while rods may form chains or exist individually.
What is the difference between Gram-positive and Gram-negative bacteria?
Gram-positive bacteria have a thick peptidoglycan layer that retains crystal violet stain and appears purple, whereas Gram-negative bacteria have a thinner peptidoglycan layer and an outer lipopolysaccharide membrane, appearing pink after staining.

Why do Gram-negative bacteria not retain crystal violet stain?
Their thinner peptidoglycan layer and outer membrane prevent retention of the dye, causing them to be counterstained with safranin.
How do Gram-positive and Gram-negative bacteria differ structurally?
Gram-positive bacteria have thick, multilayered peptidoglycan and no outer membrane, while Gram-negative bacteria have thin peptidoglycan, an outer membrane, and a periplasmic space.
How does bacterial structure affect antibiotic susceptibility?
Gram-positive bacteria are generally more susceptible to certain antibiotics like penicillin due to exposed peptidoglycan, while Gram-negative bacteria are more resistant due to their outer membrane barrier.
What are gaseous requirements for bacteria?
Bacteria can be classified based on oxygen use as aerobes, facultative anaerobes, anaerobes, or strict anaerobes.
What is an aerobe?
An aerobe is a bacterium that requires oxygen for growth and metabolism.
What is a facultative anaerobe?
A facultative anaerobe can grow in both the presence and absence of oxygen, making it highly adaptable.
What is an anaerobe?
An anaerobe grows in the absence of oxygen but is not necessarily harmed by its presence.
What is a strict anaerobe?
A strict anaerobe cannot survive in the presence of oxygen, as it is toxic to the organism.
What are bacterial nutritional patterns?
Bacteria can be autotrophic, producing their own food through photo- or chemosynthesis, or heterotrophic, requiring external sources of nutrients.
What is a commensal organism?
A commensal organism lives on or within a host without causing harm.
What is an opportunistic pathogen?
An opportunistic pathogen is normally harmless but can cause disease when the host’s immune system is compromised.
What is a pathogen?
A pathogen is a microorganism that causes disease and damages the host.
What is general growth media?
General growth media allow most microorganisms to grow and can be either defined (known composition) or undefined.
What is selective media?
Selective media allow certain organisms to grow while inhibiting others through factors like antibiotics, salts, or dyes.

What is differential media?
Differential media allow multiple organisms to grow but distinguish them based on visible differences such as color or growth patterns.

What is Mannitol Salt Agar (MSA)?
MSA is a selective and differential medium that selects for Gram-positive bacteria due to high salt concentration and differentiates based on mannitol fermentation.
How does MSA differentiate bacteria?
It contains mannitol and a pH indicator (phenol red), where fermentation produces acid, turning the medium yellow.
How do Staphylococcus aureus and Staphylococcus epidermidis differ on MSA?
S. aureus ferments mannitol and produces yellow colonies, while S. epidermidis does not ferment mannitol and remains pink/red.

What is Eosin Methylene Blue (EMB) agar?
EMB is a selective and differential medium that selects for Gram-negative bacteria and differentiates based on lactose fermentation.
How does EMB differentiate bacteria?
Lactose fermenters produce dark purple/black colonies, sometimes with a metallic green sheen, while non-fermenters remain colorless.
What is an antimicrobial?
An antimicrobial is any substance that kills or inhibits the growth of microorganisms with minimal harm to the host.
What is an antibiotic?
An antibiotic is a natural substance produced by microorganisms that inhibits or kills other microorganisms.
What is the difference between microbicidal and microbiostatic agents?
Microbicidal agents kill microorganisms directly, while microbiostatic agents inhibit growth and rely on the host’s immune system to eliminate the pathogen.
How are antimicrobial agents classified?
They are classified based on the type of organism they target (antibacterial, antifungal, antiviral, antiparasitic) and their spectrum of activity.
What is a broad-spectrum antimicrobial?
A broad-spectrum antimicrobial acts against a wide range of microorganisms, including both Gram-positive and Gram-negative bacteria.
What are advantages of broad-spectrum antibiotics?
They can be used when the exact pathogen is unknown, providing immediate treatment coverage.
What is a narrow-spectrum antimicrobial?
A narrow-spectrum antimicrobial targets a specific group of microorganisms.
What are advantages of narrow-spectrum antibiotics?
They reduce damage to normal flora and lower the risk of developing antibiotic resistance.
What are antimicrobial drugs used for?
They are used to prevent or treat infections caused by pathogenic microorganisms.
What determines whether a drug is bacteriostatic or bactericidal?
This depends on drug concentration, the organism’s susceptibility, and the host’s immune status.
When are bactericidal drugs preferred?
They are preferred in severe infections or when the immune system is compromised because they directly kill bacteria.
What is prophylactic antibiotic use?
Prophylactic use involves administering antibiotics before or during surgery to prevent infection, typically as a single perioperative dose.
What is therapeutic antibiotic use?
Therapeutic use involves administering antibiotics after infection has developed, often over several days.
When is prophylactic antibiotic use most common?
It is most common in surgeries with low infection risk to prevent contamination.
When is therapeutic antibiotic use necessary?
It is used in high-risk situations where infection is present or likely to develop.
What is selective toxicity?
Selective toxicity refers to the ability of an antimicrobial drug to specifically target and harm microbial cells while causing minimal damage to the host’s cells, which is the fundamental principle that makes antimicrobial therapy possible.

Why is selective toxicity possible?
Selective toxicity is possible because microbial cells differ from host cells in key structural and biochemical ways, such as having unique cell walls, ribosomes, or metabolic pathways that drugs can specifically target.
What are examples of targets for selective toxicity?
Common targets include bacterial cell walls, protein synthesis machinery (ribosomes), nucleic acid synthesis pathways, and metabolic pathways that are absent or significantly different in host cells.

Why is selective toxicity more difficult in some organisms?
It is more difficult in organisms like fungi and parasites because their cells are more similar to human or animal cells, making it harder to find targets that do not also harm the host.
What is the therapeutic index?
The therapeutic index is the ratio between the toxic dose of a drug and its effective dose, indicating how safe a drug is, with a higher therapeutic index meaning greater safety.

Why is a high therapeutic index important?
A high therapeutic index is important because it means the drug can effectively treat infection without causing significant harm to the patient.

What is therapeutic effect?
The desired clinical response vs measurement of selective toxicity; measured with the median effective dose (ED50).
What is ED50?
The dose of drug that produces desired response in half the population.
What is toxic effect?
The undesired side effects in host cells, measured by median toxic or lethal dose (TD50 or LD50)
What is TD50 (humans)/LD50 (animals)?
Dose of drug that produces unwanted side effects or death in half the population.
What are the 5 main mechanisms of action of antimicrobial drugs?
Antimicrobial drugs work by inhibiting cell wall synthesis, disrupting cell membrane function, inhibiting protein synthesis, interfering with nucleic acid synthesis, or blocking essential metabolic pathways.

How do drugs that inhibit cell wall synthesis work?
These drugs prevent the formation of peptidoglycan, weakening the bacterial cell wall and causing the cell to burst due to osmotic pressure.
How do drugs that disrupt cell membranes work?
These drugs damage the integrity of microbial cell membranes, causing leakage of cellular contents and ultimately cell death.
How do protein synthesis inhibitors work?
These drugs bind to bacterial ribosomes (which differ from eukaryotic ribosomes) and prevent the production of essential proteins needed for growth and survival.
How do nucleic acid synthesis inhibitors work?
These drugs interfere with DNA replication or RNA transcription, preventing the microorganism from reproducing or functioning properly.
How do metabolic pathway inhibitors work?
These drugs block essential enzymatic pathways, such as folic acid synthesis, which bacteria must produce themselves.
What is the minimal inhibitory concentration (MIC)
MIC is the lowest concentration of an antibiotic that prevents visible growth of a microorganism after incubation, indicating the minimum amount needed to stop bacterial replication.
What does a lower MIC value indicate?
A lower MIC indicates that less drug is required to inhibit bacterial growth, meaning the antibiotic is more effective against that organism.
What is the minimal bactericidal concentration (MBC)?
MBC is the lowest concentration of an antibiotic that kills a microorganism, rather than just inhibiting its growth.
What are the two main methods of antibiotic susceptibility testing?
The two main methods are the Kirby-Bauer disk diffusion test (solid media) and the broth dilution method (liquid media).
What is the Kirby-Bauer disk diffusion test?
It is a susceptibility test where antibiotic-impregnated disks are placed on an agar plate inoculated with bacteria to observe how well the antibiotic inhibits growth.
What is a zone of inhibition?
A zone of inhibition is the clear area around an antibiotic disk where bacteria fail to grow, indicating the drug is effective at inhibiting that organism. A larger zone indicates greater bacterial susceptibility to the antibiotic, meaning the drug is more effective.
What are advantages of the Kirby-Bauer test?
It is simple, cost-effective, and allows comparison of multiple antibiotics at once.
What are limitations of the Kirby-Bauer test?
It provides qualitative results (susceptible, intermediate, resistant) rather than precise concentration values like MIC.
What is the broth dilution susceptibility test?
It is a quantitative method that determines the MIC and MBC by exposing bacteria to a series of increasing antibiotic concentrations in liquid culture.
How is MIC determined in the broth dilution test?
MIC is identified as the lowest antibiotic concentration where no visible bacterial growth occurs in the tube.
How is MBC determined in the broth dilution test?
Samples from tubes with no visible growth are plated on antibiotic-free media, and the MBC is the lowest concentration where bacteria fail to regrow.
What is the advantage of the broth dilution method?
It provides precise quantitative data (MIC and MBC), allowing more accurate determination of drug effectiveness.
What is a limitation of the broth dilution method?
It is more time-consuming and labor-intensive compared to disk diffusion.
What is antimicrobial resistance?
Antimicrobial resistance is the ability of microorganisms to survive and grow despite the presence of drugs that would normally kill or inhibit them.
Why is antimicrobial resistance a major concern?
It reduces the effectiveness of treatments, increases the spread of infections, and can lead to higher morbidity and mortality.
What are the main mechanisms of antimicrobial resistance?
Decreased uptake, modification of antibiotic targets, drug efflux, inactivation or degradation of drug, use of alternative metabolic pathways.

How do bacteria acquire resistance?
Resistance can arise through spontaneous mutations or by acquiring genes from other bacteria via horizontal gene transfer.
What is horizontal gene transfer?
It is the transfer of genetic material between bacteria through mechanisms such as transformation, transduction, and conjugation.

What is transformation?
Transformation is the uptake of free DNA from the environment by a bacterium.
What is transduction?
Transduction is the transfer of DNA between bacteria via bacteriophages (viruses that infect bacteria).
What is conjugation?
Conjugation is the transfer of genetic material between bacteria through direct cell-to-cell contact via a pilus.
What is misuse of antibiotics?
Misuse includes overuse, incorrect dosing, or unnecessary use of antibiotics, which accelerates the development of resistance.
Why should broad-spectrum antibiotics be used cautiously?
They can disrupt normal microbiota and promote the development of resistant organisms.
What is superinfection?
A superinfection occurs when normal microbiota are disrupted, allowing opportunistic pathogens to overgrow.
Why is completing antibiotic courses important?
Completing the full course ensures all bacteria are eliminated, reducing the chance that resistant strains survive and multiply.
What is the difference between inpatient and outpatient surgery?
Inpatient surgery requires hospital admission and typically an overnight stay for monitoring and recovery, whereas outpatient surgery does not require admission and the patient can leave the same day.
What characterizes inpatient surgery?
Inpatient surgery involves more invasive procedures performed in an operating room, often entering body cavities and breaching protective membranes such as the pleural, peritoneal, or meningeal layers.
Why are inpatient surgeries considered higher risk?
They are higher risk because they involve major anatomical disruption, organ removal or alteration, and are often performed on patients with more serious health conditions.
What characterizes outpatient surgery?
Outpatient surgery involves minimally invasive procedures that typically only affect the skin, mucous membranes, or connective tissue and do not require overnight monitoring.
What are examples of outpatient procedures?
Examples include vascular catheter placement, ear/nose/throat procedures, ocular procedures, and surgeries involving extremities.
What does the suffix “-ectomy” mean in surgical terminology?
“-ectomy” refers to the surgical removal or excision of a structure, such as a hysterectomy (removal of the uterus) or tonsillectomy (removal of tonsils).
What does “-otomy” mean?
“-otomy” refers to cutting into an organ or tissue, such as a laparotomy (cutting into the abdomen) or craniotomy (cutting into the skull).
What does “-ostomy” mean?
“-ostomy” refers to the creation of an opening (stoma), such as a colostomy, where an opening is made in the colon.
What does “-plasty” mean?
“-plasty” refers to surgical modification or reshaping of a structure, such as rhinoplasty (nose reshaping).
What does “-oscopy” mean?
“-oscopy” refers to procedures involving insertion of an endoscope to visualize internal structures.
What is open surgery?
Open surgery is a traditional surgical approach involving large incisions to provide direct visualization and access to internal structures.
When is open surgery necessary?
It is used when minimally invasive techniques are not feasible, such as when greater visualization or access is required for diagnosis or treatment.
What is endoscopic surgery?
Endoscopic surgery is a minimally invasive technique that uses a scope and specialized instruments inserted through small incisions or natural body openings.
Why is endoscopic surgery often preferred?
It is preferred because it results in less tissue damage, faster recovery, reduced pain, and fewer complications compared to open surgery.
What are advantages of endoscopic surgery?
Advantages include smaller incisions, less pain, reduced need for pain medication, shorter recovery time, reduced blood loss, lower infection risk, decreased scarring, and less antibiotic use.

Through what routes can endoscopic surgery be performed?
It can be performed through natural body openings such as the gastrointestinal, respiratory, or urogenital tracts, or through small surgical incisions.
What tools are used in endoscopic surgery?
Tools include an endoscope with a fiber optic camera and light, along with small instruments such as forceps, scissors, suction devices, and balloons.